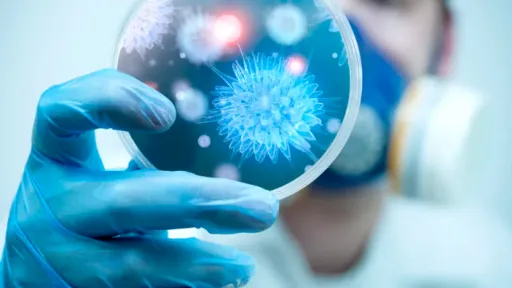

Centrul pentru Controlul şi Prevenirea Bolilor din Statele Unite (CDC) a identificat o variantă rară de gripă care prezintă rezistenţă la fosfatul de oseltamivir, cunoscut sub numele de Tamiflu, conform CNN. Această variantă, caracterizată prin două mutaţii, a ridicat preocupări cu privire la impactul său potenţial asupra eficacităţii tratamentului împotriva gripei, scrie mediafax.ro.
Dr. Andy Pekosz, virolog la Şcoala de Sănătate Publică Johns Hopkins Bloomberg, a subliniat importanţa supravegherii globale pentru monitorizarea unor astfel de mutaţii datorită potenţialelor lor implicări asupra strategiilor de tratament împotriva gripei. În ciuda prezenţei sale în 15 ţări de pe cinci continente, inclusiv două cazuri în SUA, varianta rămâne neobişnuită, reprezentând doar aproximativ 1% din eşantioanele colectate între mai 2023 şi februarie 2024.
Varianta dublă mutantă a demonstrat o reducere a eficacităţii Tamiflu de până la 16 ori în studiile de laborator, deşi implicaţiile sale clinice rămân incerte. Dr. William Schaffner de la Universitatea Vanderbilt a menţionat că dozele existente de Tamiflu ar putea totuşi să fie suficiente pentru gestionarea infecţiilor cauzate de această variantă.
Din fericire, testele de laborator indică faptul că noi antivirale precum baloxavir marboxil (Xofluza) rămân eficiente împotriva acestor mutaţii duble. În plus, şi vaccinurile antigripale ar trebui să ofere protecţie împotriva infecţiilor provocate de virusurile care poartă aceste mutaţii.
CDC a asigurat că nu există modificări imediate în recomandările de îngrijire clinică din cauza acestei descoperiri. Supravegherea globală continuă a virusologiei va continua să informeze răspunsurile şi strategiile de sănătate publică pentru a aborda potenţialele ameninţări ale virusurilor gripale cu susceptibilitate antivirală modificată.
Pe măsură ce cercetarea progresează, insuflarea unor noi perspective asupra implicărilor clinice ale acestei variante rare de gripă va fi crucială pentru modelarea viitoarelor strategii de management al gripei la nivel mondial.